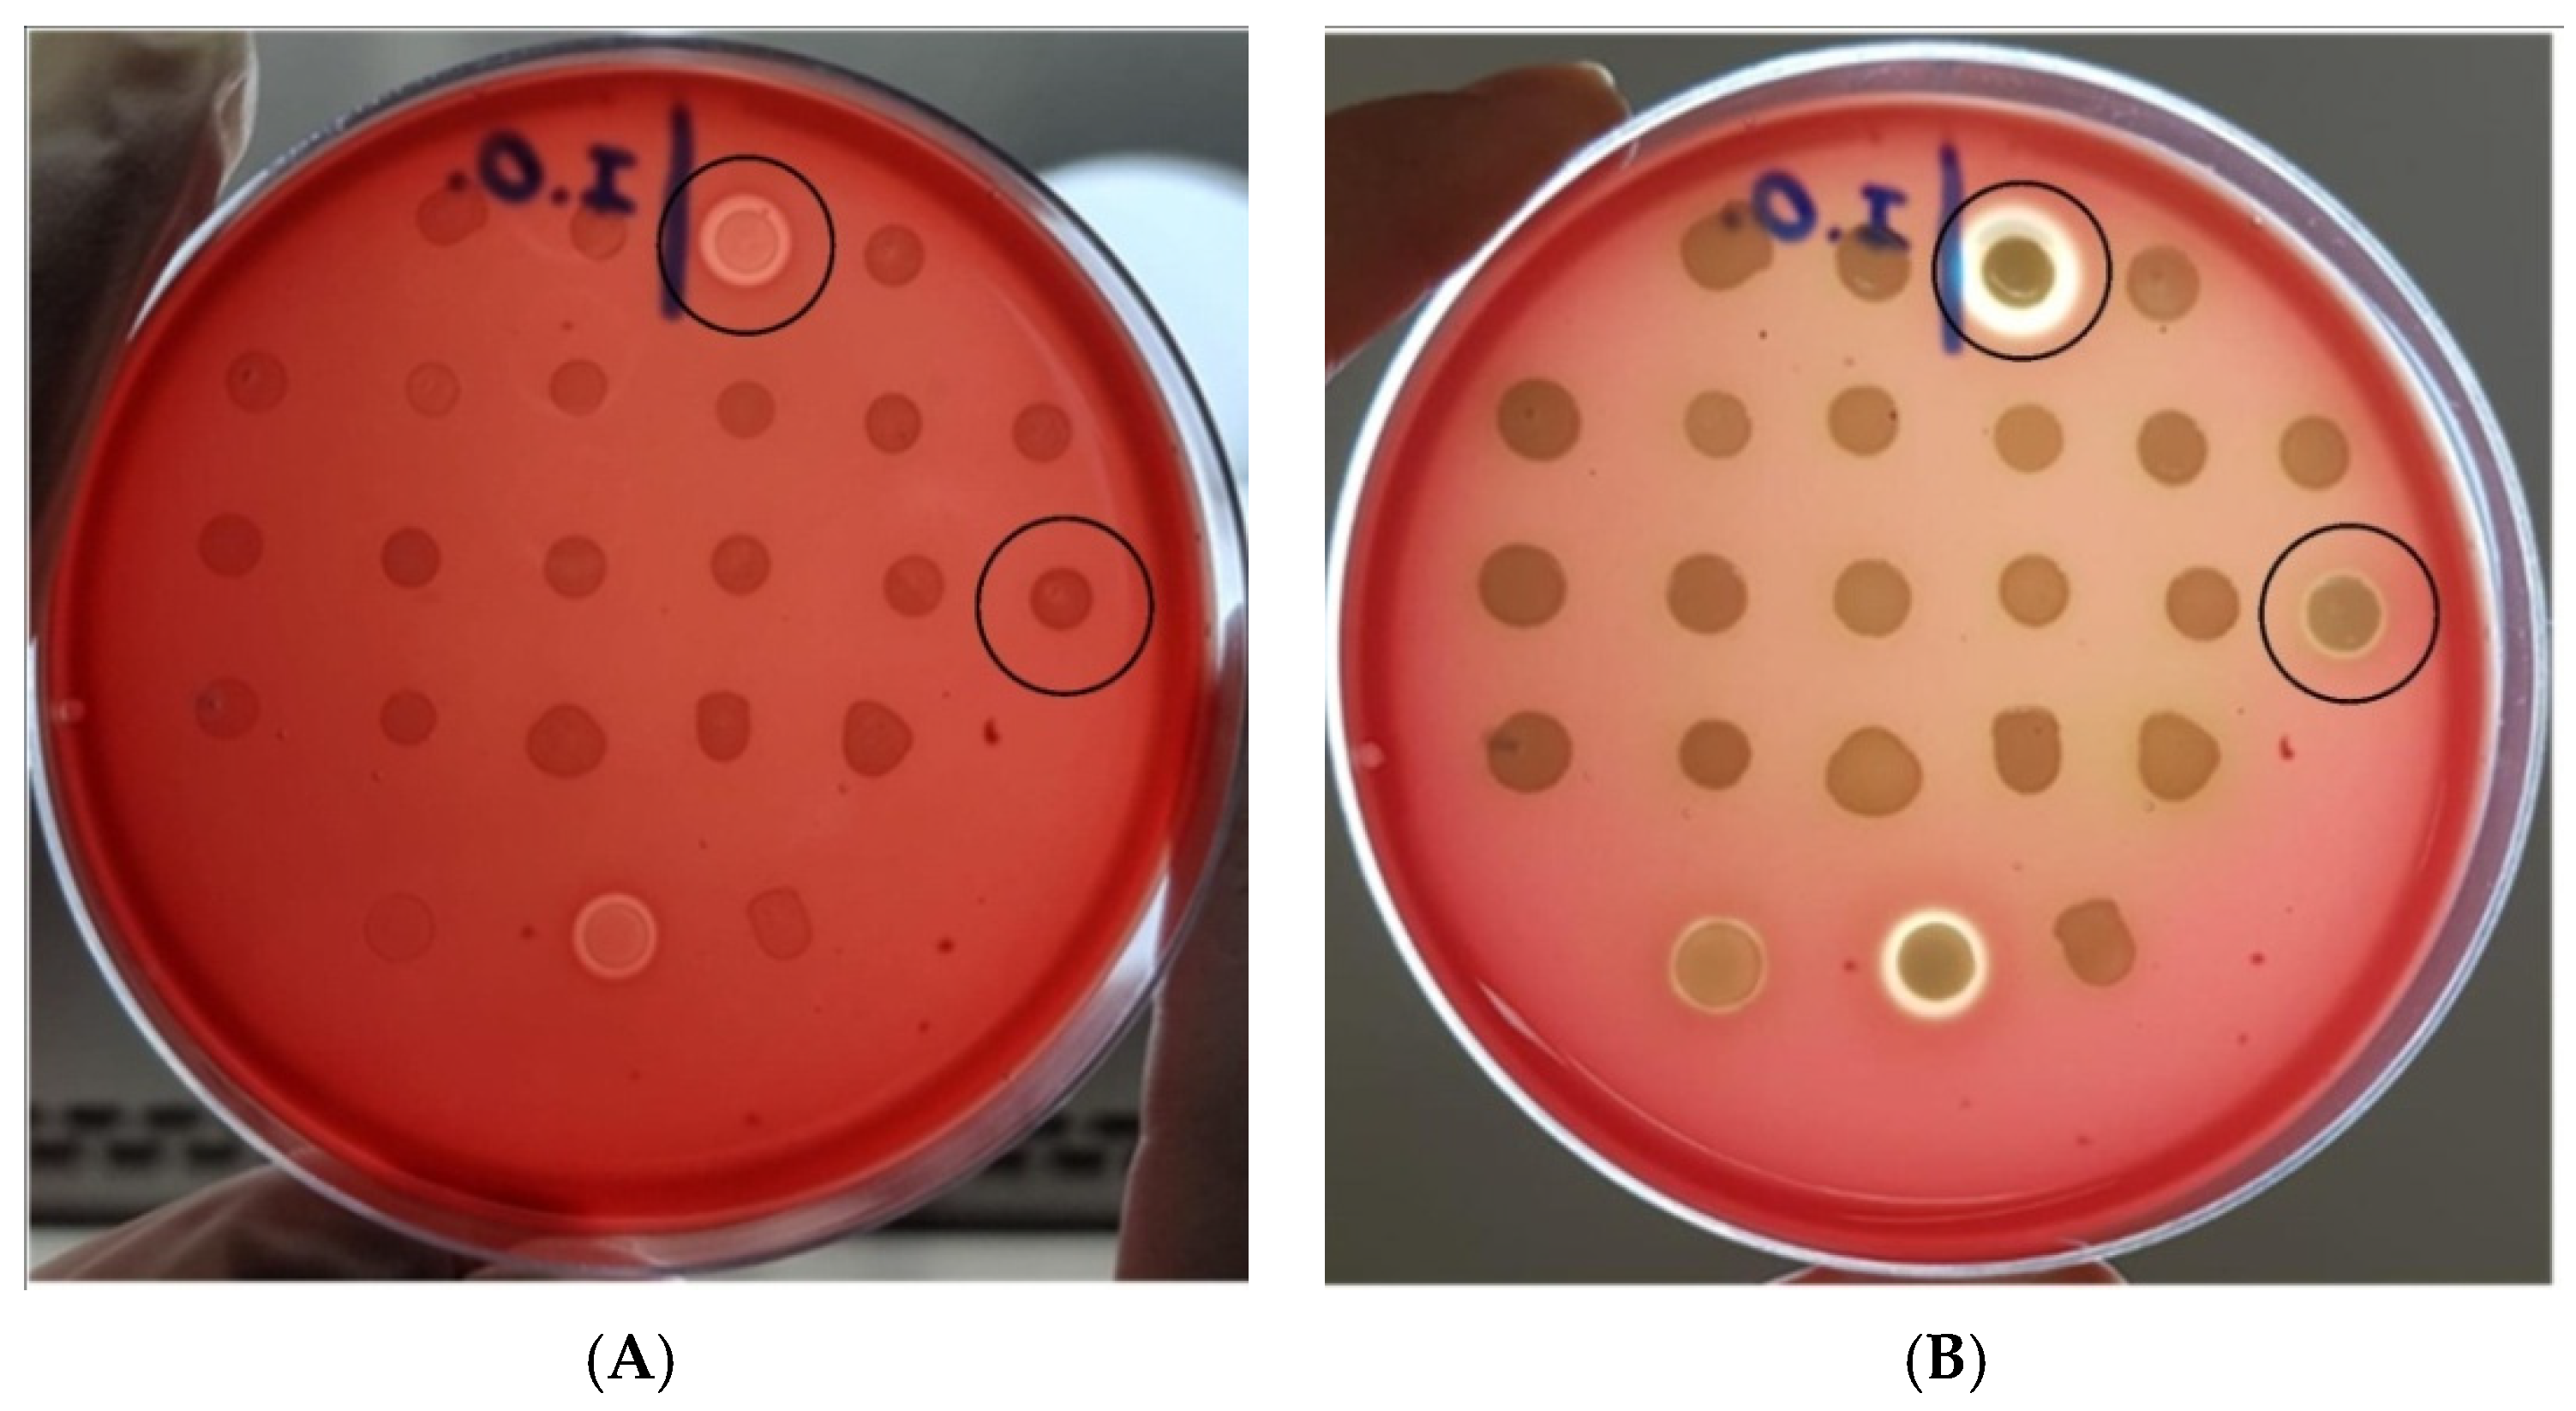
Microorganisms 10 01084 g002

Abstract
While primarily Gram-positive bacteria cause bacterial eye infections, several Gram-negative species also pose eye health risks. Currently, few studies have tried to understand the pathogenic mechanisms involved in E. coli eye infections. Therefore, this study aimed to establish the pathogenic potential of E. coli strains isolated from eye infections. Twenty-two strains isolated between 2005 and 2019 from patients with keratitis or conjunctivitis were included and submitted to traditional polymerase chain reactions (PCR) to define their virulence profile, phylogeny, clonal relationship, and sequence type (ST). Phenotypic assays were employed to determine hemolytic activity, antimicrobial susceptibility, and adhesion to human primary corneal epithelial cells (PCS-700-010). The phylogenetic results indicated that groups B2 and ST131 were the most frequent. Twenty-five virulence genes were found among our strains, with ecp, sitA, fimA, and fyuA being the most prevalent. Two strains presented a hemolytic phenotype, and resistance to ciprofloxacin and ertapenem was found in six strains and one strain, respectively. Regarding adherence, all but one strains adhered in vitro to corneal cells. Our results indicate significant genetic and virulence variation among ocular strains and point to an ocular pathogenic potential related to multiple virulence mechanisms.
1. Introduction
Bacteria are among the most relevant pathogens in ophthalmology, being responsible for numerous eye diseases, such as blepharitis, conjunctivitis, keratitis, and endophthalmitis. It is known that a healthy ocular surface contains a paucibacterial microbiota [1,2] and that some factors such as the misuse of contact lenses, bad hygiene, eye injuries, and a compromised immunologic system may favor the growth of potentially pathogenic species [3]. While Gram-positive species are more frequently identified as causative agents in eye infections, Gram-negative species also pose a threat to ocular health [1,2,3].
Escherichia coli, a member of the Enterobacteriaceae family and the Enterobacterales order, is a Gram-negative bacillus found mainly in the human gut microbiota, but that may also be found in other sites such as the human eye. However, its presence on this site remains not quite well explained [1]. Strains of E. coli can be classified as commensal or pathogenic, with commensal strains establishing a symbiotic relationship with the human host. In contrast, pathogenic strains may carry many virulence markers that, in turn, enable their capacity to cause diseases in intestinal or extraintestinal sites [4,5].
Pathogenic E. coli strains can be classified depending on the infection site and divided into pathotypes, primarily based on the virulence markers they might carry but also on phenotypic characteristics. Strains capable of causing intestinal infections are classified as intestinal pathogenic E. coli (InPEC) and are further divided into the following pathotypes: typical and atypical enteropathogenic E. coli (EPEC), Shiga toxin-producing E. coli (STEC), enterotoxigenic E. coli (ETEC), typical and atypical enteroaggregative E. coli (EAEC), enteroinvasive E. coli (EIEC), diffusely adherent E. coli (DAEC), and adherent-invasive E. coli (AIEC) [6,7,8]. Strains related to extraintestinal infections can be classified according to their site of isolation, namely uropathogenic E. coli (UPEC), neonatal meningitis-associated E. coli (NMEC), and septicemic E. coli (SEPEC) [9].
Extraintestinal pathogenic Escherichia coli (ExPEC) strains can carry a plethora of virulence genes that enable their survival on extraintestinal sites. Based on animal models of virulence, Johnson et al. [10] proposed that ExPEC strains with full virulence potential, that is, capable of infecting immunocompetent individuals, should simultaneously carry at least two out of five previously specific virulence markers—namely, pap, sfa, afa/dra, iuc/iut, and kpsMTII. Furthermore, Spurbeck et al. [11] proposed that the simultaneous presence of the genes chuA, fyuA, vat, and yfcV are epidemiologically related to uropathogenicity. It is important to notice that, despite these proposals, E. coli strains devoid of all these virulence markers may also cause extraintestinal infections [12].
In recent times, an interest in “hybrid” E. coli strains has emerged. A hybrid E. coli strain is defined by the presence in a single strain of a combination of virulence markers previously believed to be found only in specific intestinal or extraintestinal E. coli pathotypes [13]. Besides likely resulting in increased pathogenic potential, the hybrid genotype may also confer the ability to a single strain to infect and cause intestinal and extraintestinal diseases [14,15,16], thus reinforcing the importance of surveillance among pathogenic E. coli strains. However, due to their recent discovery, the frequency of hybrid strains in a clinical setting is yet to be defined.
E. coli can be considered a relevant ocular pathogen, but the origins of ocular pathogenic E. coli and the mechanisms involved in the ocular pathogenicity of ExPECs are not quite well defined, mainly due to the lack of published works on this theme. Furthermore, the genetics of ocular E. coli strains are largely understudied, and more studies are required to understand better the genetic evolution of these strains. Therefore, our main goal was to analyze the genotypic and phenotypic characteristics of E. coli strains isolated from eye infections.
2. Materials and Methods
2.1. Ethics
This retrospective study was approved by the Ethics Committee of the Federal University of São Paulo/UNIFESP, São Paulo, Brazil (CEP 7829241219 (31 December 2019)). For this study, formal consent was not required as all strains used were collected during a clinical routine at the Hospital São Paulo and kept in a microbiological bank at the Ophthalmology Laboratory (LOFT) after routine laboratory procedures.
2.2. Bacterial Strains
Twenty-two strains were isolated from April 2005 to June 2019 from patients diagnosed with keratitis or conjunctivitis at Hospital São Paulo (HSP), UNIFESP. Five strains were isolated from corneal scrapings obtained from five patients with infectious keratitis, and sixteen were isolated from conjunctival swabs from fourteen patients with infectious conjunctivitis. One strain was isolated from the contact lenses of a patient with keratitis. All collected strains were stored at −80 °C for research purposes. Strains used in this study were labeled following the resulting disease—K for keratitis and C for conjunctivitis. Strains C-3a and C-3b were obtained from a single patient, but both strains were included in this study, based on their molecular and morphological divergences. All strains were cultivated in lysogeny broth (LB) and MacConkey agar to verify their purity. Species-level identification was confirmed using the Matrix-Assisted Laser Desorption Ionization—Time of Flight—Mass Spectrometry (MALDI-TOF MS) technique, performed in the Microflex LT mass spectrometer (Bruker Daltonics, Billerica, MA, USA). Clinical details from patients are presented in Supplementary Data (Table S1).
2.3. Phylogenetic Analysis, Clonal Relationship, and Sequence Typing
The multiplex polymerase chain reaction (PCR) method proposed by Clermont et al. [17] was employed to determine to which E. coli phylogenetic group each strain belonged. Briefly, four genes—namely chuA, yjaA, arpA, and TspE4.C2—were used in a quadruplex reaction. All PCRs in this study were prepared using GoTaq® Green Master Mix (Promega, Madison, WI, USA) with 10 pmol of primers and 1 µL of DNA template obtained by bacterial thermal lysis in sterilized water for PCR. The resulting products were analyzed through agarose gel electrophoresis (1%) in 1× Tris-Borate-EDTA (TBE) buffer, stained with ethidium bromide (10 µg/mL) for 15 min, and photo-documented in the Gel Doc XR+ Gel Documentation System (Bio-Rad, Hercules, CA, USA).
The clonal relationship of the strains was determined by Random Amplified Polymorphic DNA (RAPD). To this end, two PCRs were performed, each with a single primer, 1254 (5′-CCGCAGCCAA-3′) and 1283 (5′-GCGATCCCCA-3′). Primers were used based on previous works by Pacheco et al. [18] and Nilsen et al. [19], respectively.
The multiplex PCR proposed by Doumith et al. [20] was used to determine the Sequence Type (ST), which included the STs 131, 69, 73, and 95.
2.4. Virulence Genes Profiles
The virulence genes profiles of the strains were determined by PCR for a total of 42 virulence-associated genes, which were selected based primarily on their association with the virulence of ExPEC strains. The genes used as EPEC, EAEC, ETEC, EIEC, and STEC diagnostic markers were also included to search for possible hybrid strains. The genes were included based on Nascimento et al. [21]. All PCRs were performed following the previously described methodology.
The following genes were included in this study: afaBCIII, afaE-VIII, aggR, bfpB, bmaE, cf29A, chuA, cnf1, cvaC, eae, ecp, ehxA, eltA, escV, estA, fimA, fyuA, hlyA, hra, ibeA, iha, invE, ireA, iroN, irp2, iucD, kpsMTII, kpsMTIII, ompA, ompT, papA, papC, pic, sat, sfa DE, sitA, stx1, stx2, traT, tsh, vat, and yfcV.
2.5. Hemolytic Activity
The protocol established by Beutin et al. [22] was employed to evaluate the hemolytic activity of the strains. Briefly, the strains were first cultivated in 3 mL of Tryptic Soy Broth (TSB) at 37 °C for 18 h and subsequently inoculated on a single blood agar plate, prepared with Tryptic Soy Agar supplemented with washed sheep red blood cells (Laborclin, Brazil) (final concentration of 5%), and 10 mM CaCl2. The inoculated plate was analyzed after 3 h and 24 h of incubation at 37 °C. Strains EDL933 and CFT073 were used as positive controls for enterohemolysin and α-hemolysin, respectively, and the Klebsiella spp. strain K33 was used as a negative control.
2.6. Antibiotic Susceptibility
The Kirby-Bauer disc-diffusion method [23] was used to determine the susceptibility of all 22 strains. To do so, strains were cultivated on MacConkey agar for 24 h, at 37 °C, and their resulting colonies were diluted in saline solution (0.85%) until a 0.5 McFarland standard turbidity was attained. The resulting bacterial suspensions were inoculated onto Mueller Hinton agar plates and discs were applied with sterile forceps. Plates were then incubated for 18 h, at 37 °C. Results were interpreted according to the criteria established by the Brazilian Committee on Antimicrobial Susceptibility Testing (BrCAST/EUCAST). The breakpoints used were those defined by the European Committee on Antimicrobial Susceptibility Testing (EUCAST) (https://www.eucast.org/ (accessed on 13 November 2021)). The following antimicrobials were tested: amikacin, aztreonam, cefepime, cefoxitin, cefotaxime, ceftazidime, ciprofloxacin, gentamicin, imipenem, ertapenem, meropenem, and tigecycline.
2.7. Cell Culture and In-Vitro Adherence to Human Corneal Epithelial Cells Assay
Qualitative and quantitative assays with normal human primary corneal epithelial cells (HCECs) PCS-700-010, obtained from ATCC (ATCC, Manassas, VA, USA), were performed to evaluate the ability of E. coli strains to colonize HCECs. Primary HCECs were maintained in Dulbecco’s Modified Eagle Medium Nutrient Mixture F-12 (DMEM/F12) with GlutaMAXTM-I (Gibco, Grand Island, NY, USA) supplemented with Corneal Epithelial Cell Growth Kit (ATCC), 10% bovine fetal serum (BFS) (Gibco, Brazil), and 1× PSN antibiotic mixture (penicillin—5 mg/mL, streptomycin—5 mg/mL, and neomycin—10 mg/mL (Gibco, Carlsbad, CA, USA)). Cells were cultivated and maintained in 75 mL cell culture flasks at 37 °C in an atmosphere of 5% CO2.
For quantitative analysis, assays were performed following the protocol used by Valiatti et al. [24] with some modifications. Twenty-four-well microplates were prepared with ~105 cells/per well, and, after 72 h of incubation, the medium contained in each well was discarded and cells were washed three times with sterile phosphate-buffered saline (PBS). Then, 1 mL of DMEM/F12 with Corneal Epithelial Cell Growth Kit and 2% BFS was added to each well and subsequently inoculated with 20 µL of each bacterial suspension containing approximately 108 colony-forming unities per milliliter (CFU/mL). After 3 h incubation at 37 °C, the growth medium was discarded, and each well was washed three times with sterile PBS. Next, cell lysis was obtained by adding 1 mL of sterile double-distilled water to each well and incubating for 30 min at 37 °C. The wells’ contents were collected, serial diluted, and plated onto MacConkey agar for bacterial counting.
For qualitative assays, glass coverslips were added to each well of 24-well plates and all previously mentioned steps were repeated, except for the cell lysis process. Instead, cells were fixed with methanol at room temperature, stained with May-Grünwald and Giemsa (Merck, Darmstadt, Germany), and visualized under immersion oil light microscopy. All assays were performed in technical and biological replicates.
Strain CFT073 was used as an ExPEC positive control, and an uninfected well was considered a negative control.
3. Results
3.1. Phylogenetic Analysis, Clonal Relationship, and Sequence Typing
In total, thirteen (59%) strains were identified as belonging to the phylogenetic group B2, three to group A, two to group D, two to group F, one to group C, and one to group B1. None of the strains belonged to group E. Regarding Sequence Typing, eleven (50%) strains were identified as ST131, while the remaining strains were negative for all STs included in the quadruplex (Table 1).

Table 1.
Phylogenetic profile and sequence type of Escherichia coli strains isolated from eye infections.
Based on the sequence typing results, all eleven ST131 strains were submitted to RAPD typing. Based on the resulting profiles, two genetic clusters were identified. Strains C-3a, C-3b, C-4, and C-11 shared the same profiles with both primers, thus constituting a cluster. Strains C-8, C-9, and K-5 shared the same profiles with both primers and formed a second cluster. In addition, both clusters appeared to be genetically related to some degree since they shared an identical amplification pattern in one of the PCRs. The other strains presented distinct profiles.
By comparing phylogroup and disease, we could observe that groups B2, D, and F made up 87.5% of all conjunctivitis strains and three out of six keratitis strains (50%) were from group B2.
3.2. Virulence Genes Profile
Twenty-five (62.5%) out of the 42 genes screened were identified in at least one strain of our collection. The ecp, fyuA, sitA, fimA, ompA, and irp2 genes were the most prevalent among our strains, being present in 100% (ecp), 90.9% (sitA), 86.3% (fyuA, fimA), and 81.8% (irp2, ompA) of the strains. The iha, iucD, chuA, ompT, sat, yfcV, kpsMTII, iroN, and traT genes were also identified in a significant percentage of strains, with identification ranging from 77.2% to 50% (Figure 1). We did not identify genes associated with the InPEC pathotypes, such as eae, aggR, stx1, stx2, eltA, estA, invE, and bfpB, among our strains, thus indicating the absence of hybrid strains in our collection. Regarding the individual virulence profile of each strain, we observed that most strains—17 out of 22—carried at least 12 virulence genes. Strain C-4 carried the highest number of genes, with 18 genes.

Figure 1.
Virulence genes prevalence among Escherichia coli strains isolated from eye infections. The aggR, afaE-VIII, bfpB, bmaE, cf29A, cnf1, eae, eltA, escV, estA, invE, ireA, kpsMTIII, stx-1, and stx-2 genes were absent in all strains.
Seventeen strains presented at least two of the five intrinsic virulence markers proposed by Johnson et al. [10] to define ExPEC intrinsic virulence. Of the remaining five strains, four carried one of these markers, while strain K-2 was devoid of all five markers. Furthermore, based on Spurbeck et al. [11] proposal regarding uropathogenicity, we also screened our strains for the four virulence markers related to more efficient urinary tract colonization. In total, 12 strains were classified as potentially uropathogenic as they carried, simultaneously, at least three of the four proposed virulence markers. From these 12 strains, 10 also fell under the ExPEC intrinsic virulence classification. Moreover, K-3 and K-4 were the only strains to carry all four UPEC virulence markers (Table 2).

Table 2.
Virulence profiles of Escherichia coli strains isolated from eye infections.
3.3. Hemolytic Activity
Only two strains presented hemolytic activity, namely strains K-3 and C-15. Although both strains formed a clear halo of hemolysis around the colonies, the halo developed by the former strain was observed after 3 h of incubation, while the halo produced by the latter strain was detected only after 24 h (Figure 2). Interestingly, both strains lacked the hlyA and ehxA genes. Despite being positive for hlyA—a gene associated with the α-hemolysis phenotype—strains C-3a, C-3b, and C-4 were non-hemolytic.

Figure 2.
Blood agar plate inoculated with Escherichia coli strains isolated from eye infections (A) after 3 h of incubation; (B) after 24 h of incubation. Positive strains are circled in black. Controls at bottom row (from left to right): Shiga-toxin producing E. coli (STEC) strain EDL933 (enterohemolysin producer), UPEC strain CFT073 (alpha-hemolysin producer), and Klebsiella spp. K33 (non-hemolytic strain). The ocular E. coli strain C-3a was not included in this test.
3.4. Antibiotic Susceptibility
Fifteen (68.2%) of the strains included in the study were sensitive to all the antimicrobials tested; six (27.3%) were resistant to ciprofloxacin, one (4.5%) was resistant to ertapenem, and one (4.5%), which was resistant to ciprofloxacin, was also resistant to gentamicin (Table S2).
3.5. In-Vitro Adherence to Human Corneal Epithelial Cells
Except for C-14, all strains were able to adhere—with variable intensities—to human corneal epithelial cells. The mean interaction ranged from 105 CFU/mL to 107 CFU/mL. Among the strains, C-5 and C-15 were the most adherent, while strains C-1 and C-2 were the least adherent (Figure 3B).

Figure 3.
Adherence of Escherichia coli strains isolated from eye infections to human corneal epithelial cells (HCECs). (A) Representative examples of different levels of E. coli strains adherence to HCEC under oil immersion light microscopy: (1) strain C-8, low adherence; (2) strain C-15, high adherence; (3) strain C-6, high adherence and aggregative adherence pattern; (4) non-infected human corneal epithelial cells. (B) Bacterial adherence based on quantitative assay results. The prototype strain CFT073 was used as a control for ExPEC adherence.
Under oil immersion light microscopy, we could observe that all strains interacted with HCECs in vitro, with clearly definable differences regarding adherence level. Some strains visibly demonstrated a lower level of adherence, with only a few visible bacteria adhering to HCECs, while others presented a higher level of adherence, with bacteria distributed diffusely on cells. In addition, except for strain C-6, no specific adherence pattern was identified among the strains (Figure 3A). Curiously, strain C-6 presented a pattern that resembled the aggregative adherence pattern of EAEC strains. Following this phenotypical presentation and the virulence profile results, we also screened this strain for genes associated with atypical EAEC strains—namely aatA, aaiA, aaiC, and aaiG—but none of these genes were identified in the strain (data not shown). None of the tested strains promoted apparent morphological changes in the infected cells.
4. Discussion
The E. coli strains associated with eye infections are understudied, despite their continuous—yet not so frequent—isolation from this site [25,26,27]. To enhance the knowledge regarding this topic, in the present work, we performed a molecular and phenotypic evaluation of diverse virulence aspects in a collection of E. coli strains isolated from cases of keratitis and conjunctivitis.
It is a consensus that E. coli strains isolated from extraintestinal infections share diverse traits related to their capacity to cause infections out of the intestinal site. In this sense, phylogroup B2 is pointed out as the most frequent group associated with extraintestinal infections due to the higher prevalence of specific virulence factors related to the extraintestinal pathogenicity that these strains commonly bear [28,29].
Our phylogenetic findings are similar to those presented by several authors, in which strains of group B2, group D, and group F are more commonly associated with extraintestinal infections [8,30,31,32]. It has been proposed that group B2 is more prevalent in extraintestinal infections due to a higher prevalence of virulence genes related to extraintestinal pathogenicity [29,30,33]. This observation also correlates with our findings, given that all strains with the highest number of ExPEC virulence markers were identified as belonging to group B2. Many studies have also observed that UPEC strains are more frequently identified as belonging to group B2 than to other phylogenetic groups [34,35]. Our results align with these observations as all strains classified as potentially uropathogenic in our virulence profile analysis were from group B2. It is worth noting that strains of groups A and C also carried ExPEC virulence markers, but to a lesser extent than the previously mentioned groups. This is especially noteworthy given that, in recent years, it has been observed a more expressive presence of pathogenic strains of group A—a group primarily associated with commensal strains—in reports of extraintestinal infections caused by E. coli. Such an increase in infections caused by strains of group A has been reported not only by our group but also by other authors worldwide [14,21,36,37].
ST131 is currently the most well-established Sequence Type among E. coli strains that cause extraintestinal infections globally [38,39,40]. Furthermore, in recent years, E. coli ST131 has been considered a high-risk clone linked to increased resistance rates to fluoroquinolones and β-lactams [41,42,43]. This is also reinforced by our results, given that all strains resistant to ciprofloxacin—except for strain K-4—and ertapenem belonged to ST131. Interestingly, our results show that ST131 might also be relevant in eye infections as there are no known reports of the prevalence of eye infections caused by E. coli ST131 strains.
By comparing the virulence profiles with phylogenetic analysis, we observed that strains from groups B2 and F showed greater gene diversity and a higher number of genes per strain than those observed in other groups, thus reinforcing the notion that strains of group B2 usually carry a higher number of virulence genes, especially those associated with extraintestinal infections.
Studies assessing the distribution of virulence factors among ExPEC strains indicate a great diversity of genes with variable frequencies [12,44,45]. Due to the lack of studies regarding ocular E. coli virulence, we cannot draw a robust comparison of virulence profiles of ocular E. coli collections. However, by comparing our results to other published virulence profiles of ExPEC strains, we can observe some peculiar findings, such as the high prevalence of siderophore-encoding genes among our strains, such as iucD, irp2, and especially, sitA [46,47].
The sitA gene encodes an iron-manganese transporter that, according to some authors, is relevant to the pathogenicity of avian pathogenic E. coli [APEC] [48] and NMEC [49] strains. Its main function is to enable iron uptake and is especially important to bacterial survival in iron-deficient sites. While present in many ExPEC strains, a high prevalence such as the one presented is not usual. Regarding E. coli eye pathogenicity, this siderophore might play an important role in establishing an infection, given that the human eye surface has a very low amount of iron available and most of it is associated with lactoferrin as a measure to inhibit microbial growth [50]. These siderophores and iron-uptake systems might benefit bacterial growth by capturing all iron available on the lacrimal film and thus allowing the bacteria to infect the eye surface successfully.
Adhesins are relevant virulence factors to the pathogenesis of E. coli infections, given that they enable adhesion between bacteria and host cells. Many known genes carried by E. coli strains encode either fimbrial or afimbrial adhesins, such as pap, sfa, fim, yfcV, and afa [51,52,53]. Our strains were positive for many of these genes, with ecp, which encodes a subunit of the E. coli common pilus [54], and fimA, which encodes a subunit of the type I fimbria [55], being the first and second most prevalent among our strains, respectively. The high prevalence of fimA is relevant given the role of type I fimbria in E. coli extraintestinal diseases pathogenesis– by adhering to various types of epithelial cells, favoring biofilm-formation [56,57,58]—and evading extracellular antibiotics [59]. While it is not understood how it could affect E. coli ocular pathogenesis, it is known to confer to Serratia marcescens strains, an emerging ocular pathogen of the order Enterobacterales, the ability to adhere to HCEC in vitro [60]. Therefore, it is possible to presume that the type I fimbria might also benefit E. coli virulence in the human eye. However, it is worth mentioning that the presence of genes that are part of the fim operon is not always an indicator of its production. A simple agglutination test performed with our strains indicated that, despite the high prevalence of fimA, only nine strains—namely strains K-1, K-3, K-5, K-6, C-4, C-5, C-6, C-9, and C-10—produced the fimbria [data not shown], strongly suggesting that other adhesins might mediate adhesion to the cornea.
Lastly, ibeA is a virulence gene associated with some ExPEC pathotypes, such as NMEC, APEC, and AIEC [61,62]. It encodes an invasin that has been linked to many functions, such as invasion of brain endothelial cells [61], intramacrophage survival [62], and H2O2 stress survival [63]. Regarding pathogenicity in the human host, it is suggested to play a role in the pathogenesis of neonatal meningitis by mediating traversal of the blood-brain barrier and giving access to the bloodstream [64]. Based on our results, we cannot conclude whether the presence of ibeA affects bacterial pathogenicity in the eye. However, given its association with more severe infections, the presence of ibeA among our strains is nevertheless relevant, despite its low prevalence.
E. coli α-hemolysin (HlyA) is a cytotoxic toxin capable of lysing several cells—namely erythrocytes, leukocytes, and renal tubular cells—by forming pores in the target cell membrane [65]. It is encoded by a four-gene operon—hlyCABD—and, although the intracellular pathways of HlyA action are not entirely known for all diseases, its expression has been linked to more severe extraintestinal infections, especially UTIs [66]. Though the presence of the hlyA gene is a relevant predictor for the hemolytic phenotype, a strain that carries hlyA may be non-hemolytic, like the strains C-3a, C-3b, and C-4 in our study. It has been reported that defects in the hlyCBD operon or rfaH, a gene responsible for encoding a transcriptional activator of hemolysin synthesis, despite the presence of the hlyA gene, lead to the absence of a hemolytic phenotype [67]. The α-hemolysis phenotype presented by strain K-3 is worth noting because it lacks the hlyA gene, which probably indicates that the presented phenotype might be related to mechanisms other than HlyA production. It has been proposed that cytolysin A, a silent hemolysin encoded by the sheA/hlyE gene and found in both non-pathogenic and pathogenic E. coli strains, could be responsible for a hemolytic phenotype in strains that lack other E. coli hemolysin genes, such as genes from the hlyCABD operon, even though its role in pathogenesis is also yet to be determined [68]. Furthermore, enterohemolysin is another common E. coli hemolysin, with its name deriving from being first described in strains isolated from the fecal matter of infants with gastroenteritis [69]. Enterohemolysin is commonly associated with EHEC and STEC strains, but it can also be produced by non-EHEC/STEC strains [70]. It can be encoded by the plasmid-borne operon ehxCABD or phage-associated ehlyA gene and is phenotypically different from HlyA—it forms smaller halos that only appear after overnight incubation, in contrast with the 3 h incubation period required for HlyA [71]. Despite this phenotypical differentiation, strain C-15 could not be considered enterohemolysin positive as it lacks the enterohemolysin-encoding gene.
It is currently unknown how E. coli hemolysins would affect the eye during an infection. In some cases, the role of hemolysins in the pathogenesis of eye infections is quite well described. Studies about how hemolysins produced by other species—such as Staphylococcus aureus, Bacillus cereus, Pseudomonas aeruginosa, and Enterococcus faecalis– affect the eye do indicate that compared to non-hemolytic strains, a more aggressive infection takes place, regardless of the infected eye structure [72,73,74,75,76]. A study about the S. aureus α-hemolysin role in infectious keratitis pathogenesis observed that it prevents corneal re-epithelialization, thus preventing the healing of corneal ulcers, and is essential for intracellular bacterial invasion, even though it is not solely responsible for the invasion [72]. In another study, increased corneal opacity and leukocytic invasion of the corneal stroma were observed in vivo by injecting purified P. aeruginosa hemolysin intracorneally in rabbits [73]. In endophthalmitis models, studies about hemolytic B. cereus and E. faecalis strains indicated increased retinal damage and local immune response in eyes infected with hemolytic E. faecalis [74]. In contrast, hemolytic B. cereus caused severe retinal damage slightly faster than non-hemolytic strains [75,76]. Given those examples, it is possible to assume that, while not essential, hemolysins increase bacterial virulence in the eye and help the bacteria to thrive more quickly on the site. Furthermore, given our results, it is possible to assume that E. coli does not depend on hemolysis to infect and survive on the ocular surface, even though more studies are needed to understand if and how E. coli hemolysins affect the pathogenesis of eye infections.
In the literature, the susceptibility of E. coli isolates recovered from ocular infections to ciprofloxacin is reportedly variable. For example, in the study developed by Mohammed et al. [77], all isolates were sensitive to ciprofloxacin, whereas the studies by Getahun et al. [78] and Ranjith et al. [79] demonstrated resistance rates of 16.7% and 58%, respectively. In recent years, an increase in the number of E. coli strains resistant to ciprofloxacin has been observed. According to studies, this increase is mainly due to the dissemination of international clones ST131 (Subclones 131-H30-R and 131-H30Rx) and ST1193, which have mutations in the gyrA and parC genes that confer resistance to fluoroquinolones [80].
In contrast, other studies observed resistance phenotypes to other antimicrobials, unlike our isolates, which were multi-susceptible [77,78,79,81,82]. Worryingly, some reports have already reported multi-drug-resistant (MDR) E. coli strains mainly as a result of extended-spectrum B-lactamase (ESBL) production [25,83], which consequently limits the therapeutic options for treatment. However, it is worth noting that most eye infections are treated using topical antibiotics that, in turn, offer a localized treatment with a higher antibiotic concentration than that achieved during systemic treatment. Furthermore, it has been proposed that resistance observed with systemic breakpoints may overestimate the real potential ocular resistance [84]. Therefore, while still relevant, our results cannot indicate a possible treatment failure, as all breakpoints used are based on the antibiotic concentration found during systemic treatment.
Bacterial adherence to host cells is an essential part of pathogenesis, as it allows the bacteria to successfully colonize the infection site, despite the action of external factors. It can be mediated by many factors, such as adhesive fibers named “fimbriae” that facilitate adhesion to host cells and interbacterial aggregation [54,58,85]. Adhesion is highly relevant regarding eye infections, as the eyelids’ constant motion prevents non-adherent bacteria from colonizing the eye surface.
As previously mentioned, type I fimbria is pivotal for other species to adhere to corneal cells. In our results, most of the nine strains that produced type I fimbria presented a slightly higher adherence than strains that do not produce this fimbria. Furthermore, strain C-6 appears to produce type I fimbria and presented a higher level of adherence to corneal cells and interbacterial aggregation. All these findings might be related to the production of type I fimbria, but more studies are required to confirm this. Furthermore, our results also point to the involvement of other E. coli adhesins, with strain C-15 being an example of this. Although this strain lacks the fimA gene, it still presented a high level of adherence. Other adhesin-encoding genes carried by this strain, such as afaBCIII and yfcV, might influence its adherence to HCECs.
While the interaction between E. coli strains and human corneal cells is vastly unknown, our results indicate that ExPEC strains can adhere to corneal cells and more than one type of adhesins might mediate such adherence. Although more studies are still required to understand how E. coli adhesins work on the ocular surface, our results provide some insight into the ocular pathogenesis of E. coli.
Clinically, the uropathogenic potential of more than half of our strains might be the most relevant finding, as it might be an indicator of a possible link between UTI and eye infections. We cannot draw any conclusions regarding these findings as we did not have access to the patients’ clinical history. Therefore, we cannot know if they developed an eye infection during or shortly after a UTI.
The main limitation we faced was the scarcity of published works about ocular E. coli, as it hinders the possibility of comparing our results to those obtained from a strain of the same niche. This might make it difficult to identify patterns among ocular E. coli strains that could help us understand if there are specific characteristics shared between them. Secondly, while in vitro results are essential, there is an important gap between how a bacterial strain behaves in vitro and how it would behave in vivo, especially concerning the eye. Numerous factors that could prevent bacterial colonization are absent in an in vitro assay. Therefore, while our results point to some factors that could help bacterial colonization of the eye surface, it is not possible to firmly conclude about E. coli eye pathogenicity based solely on molecular and in vitro results.
5. Conclusions
Our findings indicate that E. coli strains isolated from eye infections display an extensive genetic variety and a considerable diversity regarding their virulence profile. In addition, the absence of strains from other pathotypes and hybrid strains might indicate that to thrive on the human eye, ExPEC virulence mechanisms, while not intrinsically required, might play an important role. Furthermore, our findings present an interesting insight into how E. coli might infect the human eye. Still, more studies are required to understand better how E. coli reaches the human eye to help prevent future infections.
Supplementary Materials
The following are available online at https://www.mdpi.com/article/10.3390/microorganisms10061084/s1, Table S1. Clinical details of patients with eye infections caused by Escherichia coli strains. Table S2. Antibiotic susceptibility profile of Escherichia coli strains isolated from eye infections.
Author Contributions
Conceptualization, P.H.S.N., T.B.V. and T.A.T.G.; methodology, P.H.S.N., T.B.V., J.A.d.S.N., J.F.S.-N. and A.C.d.M.S.; formal analysis, P.H.S.N., T.B.V. and A.C.d.M.S.; resources, T.T.R., M.C.Z.Y., A.L.H.-L. and T.A.T.G.; writing—original draft preparation, P.H.S.N. and T.B.V.; writing—review and editing, T.B.V., A.C.d.M.S., T.T.R., A.L.H.-L. and T.A.T.G.; visualization, P.H.S.N.; supervision, T.B.V., A.C.d.M.S. and T.A.T.G.; project administration, A.L.H.-L. and T.A.T.G.; funding acquisition, T.A.T.G. All authors have read and agreed to the published version of the manuscript.
Funding
This research was funded by the National Council for Science and Technological Development (CNPq), grant number 311283/2020-9. The APC was funded by Fundação de Amparo à Pesquisa do Estado de São Paulo (FAPESP) (2017/14821-7). We are grateful to CNPq for also providing scholarship to P.H.S.N. (PIBIC) and to FAPESP for also providing scholarship to T.B.V. (Process number: 2017/21947-7).
Institutional Review Board Statement
This study was conducted according to the guidelines of the Declaration of Helsinki and approved by the Ethics Committee of Universidade Federal de São Paulo/UNIFESP, São Paulo, Brazil (CEP 7829241219 (31 December 2019)).
Informed Consent Statement
All strains used in this study were obtained from clinical routine after laboratory procedures. No additional procedure was performed to acquire any bacterial strain, so consent was not required as determined by the Brazilian National Health Council nº 466/12 and 510/16. All patient information was obtained from anonymized medical records.
Data Availability Statement
Not applicable.
Acknowledgments
We would like to thank the Alerta Laboratory for its assistance in carrying out the antimicrobial susceptibility test.
Conflicts of Interest
The authors declare no conflict of interest. The funders had no role in the design of the study; in the collection, analyses, or interpretation of data; in the writing of the manuscript, or in the decision to publish the results.
References
- Willcox, M.D. Characterization of the normal microbiota of the ocular surface. Exp. Eye Res. 2013, 117, 99–105. [Google Scholar] [CrossRef] [PubMed]
- Petrillo, F.; Pignataro, D.; Lavano, M.A.; Santella, B.; Folliero, V.; Zannella, C.; Astarita, C.; Gagliano, C.; Franci, G.; Avitabile, T.; et al. Current evidence on the ocular surface microbiota and related diseases. Microorganisms 2020, 8, 1033. [Google Scholar] [CrossRef] [PubMed]
- Teweldemedhin, M.; Gebreyesus, H.; Atsbaha, A.H.; Asgedom, S.W.; Saravanan, M. Bacterial profile of ocular infections: A systematic review. BMC Ophthalmol. 2017, 17, 212. [Google Scholar] [CrossRef] [PubMed]
- Kaper, J.B.; Nataro, J.P.; Mobley, H.L.T. Pathogenic Escherichia coli. Nat. Rev. Microbiol. 2004, 2, 123–140. [Google Scholar] [CrossRef] [PubMed]
- Dale, A.P.; Woodford, N. Extra-intestinal pathogenic Escherichia coli (ExPEC): Disease, carriage and clones. J. Infect. 2015, 71, 615–626. [Google Scholar] [CrossRef]
- Nataro, J.P.; Kaper, J.B. Diarrheagenic Escherichia coli. Clin. Microbiol. Rev. 1998, 11, 142–201. [Google Scholar] [CrossRef]
- Darfeuille-Michaud, A.; Boudeau, J.; Bulois, P.; Neut, C.; Glasser, A.-L.; Barnich, N.; Bringer, M.-A.; Swidsinski, A.; Beaugerie, L.; Colombel, J.-F. High prevalence of adherent-invasive Escherichia coli associated with ileal mucosa in Crohn’s disease. Gastroenterology 2004, 127, 412–421. [Google Scholar] [CrossRef]
- Denamur, E.; Clermont, O.; Bonacorsi, S.; Gordon, D. The population genetics of pathogenic Escherichia coli. Nat. Rev. Genet. 2020, 19, 37–54. [Google Scholar] [CrossRef]
- Johnson, J.R.; Russo, T.A. Molecular Epidemiology of Extraintestinal Pathogenic Escherichia coli. EcoSal Plus 2018, 8. [Google Scholar] [CrossRef]
- Johnson, J.R.; Kuskowski, M.A.; Owens, K.; Gajewski, A.; Winokur, P. Phylogenetic Origin and Virulence Genotype in Relation to Resistance to Fluoroquinolones and/or Extended—Spectrum Cephalosporins and Cephamycins among Escherichia coli Isolates from Animals and Humans. J. Infect. Dis. 2003, 188, 759–768. [Google Scholar] [CrossRef]
- Spurbeck, R.R.; Dinh, P.C., Jr.; Walk, S.T.; Stapleton, A.E.; Hooton, T.M.; Nolan, L.K.; Kim, K.S.; Johnson, J.R.; Mobley, H.L. Escherichia coli isolates that carry vat, fyuA, chuA, and yfcV efficiently colonize the urinary tract. Infect Immun. 2012, 80, 4115–4122. [Google Scholar] [CrossRef] [PubMed]
- Santos, A.C.M.; Zidko, A.C.M.; Pignatari, A.C.; Silva, R.M. Assessing the diversity of the virulence potential of Escherichia coli isolated from bacteremia in São Paulo, Brazil. Braz. J. Med. Biol. Res. 2013, 46, 968–973. [Google Scholar] [CrossRef] [PubMed]
- Santos, A.C.M.; Santos, F.F.; Silva, R.M.; Gomes, T.A.T. Diversity of Hybrid- and Hetero-Pathogenic Escherichia coli and their potential implication in more severe diseases. Front. Cell. Infect. Microbiol. 2020, 10, 339. [Google Scholar] [CrossRef] [PubMed]
- Mariani-Kurkdjian, P.; Lemaître, C.; Bidet, P.; Perez, D.; Boggini, L.; Kwon, T.; Bonacorsi, S. Haemolytic-uraemic syndrome with bacteraemia caused by a new hybrid Escherichia coli pathotype. New Microbes New Infect. 2014, 2, 127–131. [Google Scholar] [CrossRef]
- Kessler, R.; Nisa, S.; Hazen, T.H.; Horneman, A.; Amoroso, A.; Rasko, D.A.; Donnenberg, M.S. Diarrhea, bacteremia and multiorgan dysfunction due to an extraintestinal pathogenic Escherichia coli strain with enteropathogenic E. coli genes. Pathog. Dis. 2015, 73, ftv076. [Google Scholar] [CrossRef] [PubMed]
- Gati, N.S.; Middendorf-Bauchart, B.; Bletz, S.; Dobrindt, U.; Mellmann, A. Origin and Evolution of Hybrid Shiga Toxin-Producing and Uropathogenic Escherichia coli Strains of Sequence Type 141. J. Clin. Microbiol. 2019, 58, e01309-19. [Google Scholar] [CrossRef]
- Clermont, O.; Christenson, J.K.; Denamur, E.; Gordon, D.M. The Clermont Escherichia coli phylo-typing method revisited: Improvement of specificity and detection of new phylo-groups. Environ. Microbiol. Rep. 2013, 5, 58–65. [Google Scholar] [CrossRef]
- Pacheco, A.B.F.; Guth, B.E.C.; Scares, K.C.C.; De Almeida, D.F.; Ferreira, L.C.S. Clonal relationships among Escherichia coli serogroup O6 isolates based on RAPD. FEMS Microbiol. Lett. 1997, 148, 255–260. [Google Scholar] [CrossRef]
- Nielsen, K.L.; Dynesen, P.; Larsen, P.; Frimodt-Møller, N. Faecal Escherichia coli from patients with E. coli urinary tract infection and healthy controls who have never had a urinary tract infection. J. Med. Microbiol. 2014, 63, 582–589. [Google Scholar] [CrossRef]
- Doumith, M.; Day, M.; Ciesielczuk, H.; Hope, R.; Underwood, A.; Reynolds, R.; Wain, J.; Livermore, D.M.; Woodford, N. Rapid Identification of Major Escherichia coli Sequence Types Causing Urinary Tract and Bloodstream Infections. J. Clin. Microbiol. 2015, 53, 160–166. [Google Scholar] [CrossRef]
- Nascimento, J.A.S.; Santos, F.F.; Santos-Neto, J.F.; Trovão, L.O.; Valiatti, T.B.; Pinaffi, I.C.; Vieira, M.A.M.; Silva, R.M.; Falsetti, I.N.; Santos, A.C.M.; et al. Molecular Epidemiology and Presence of Hybrid Pathogenic Escherichia coli among Isolates from Community-Acquired Urinary Tract Infection. Microorganisms 2022, 10, 302. [Google Scholar] [CrossRef] [PubMed]
- Beutin, L.; Montenegro, M.A.; Orskov, I.; Orskov, F.; Prada, J.; Zimmermann, S.; Stephan, R. Close association of verotoxin (Shiga-like toxin) production with enterohemolysin production in strains of Escherichia coli. J. Clin. Microbiol. 1989, 27, 2559–2564. [Google Scholar] [CrossRef] [PubMed]
- Bauer, A.W.; Kirby, W.M.M.; Sherris, J.C.; Turck, M. Antibiotic Susceptibility Testing by a Standardized Single Disk Method. Am. J. Clin. Pathol. 1966, 45, 493–496. [Google Scholar] [CrossRef] [PubMed]
- Valiatti, T.B.; Santos, F.F.; Santos, A.C.M.; Nascimento, J.A.S.; Silva, R.M.; Carvalho, E.; Sinigaglia, R.; Gomes, T.A.T. Genetic and Virulence Characteristics of a Hybrid Atypical Enteropathogenic and Uropathogenic Escherichia coli (aEPEC/UPEC) Strain. Front. Cell. Infect. Microbiol. 2020, 10, 492. [Google Scholar] [CrossRef] [PubMed]
- Van Tyne, D.; Ciolino, J.B.; Wang, J.; Durand, M.L.; Gilmore, M.S. Novel Phagocytosis-Resistant Extended-Spectrum β-Lactamase-Producing Escherichia coli From Keratitis. JAMA Ophthalmol. 2016, 134, 1306–1309. [Google Scholar] [CrossRef][Green Version]
- Yang, W.; Shen, L.; Wang, A.; Li, M.; Yang, C. Bacterial Culture of Tear Duct Infections Secondary to Congenital Nasolacrimal Duct Obstructions. J. Ophthalmol. 2022, 2022, 9954634. [Google Scholar] [CrossRef]
- Manente, R.; Santella, B.; Pagliano, P.; Santoro, E.; Casolaro, V.; Borrelli, A.; Capunzo, M.; Galdiero, M.; Franci, G.; Boccia, G. Prevalence and Antimicrobial Resistance of Causative Agents to Ocular Infections. Antibiotics 2022, 11, 463. [Google Scholar] [CrossRef]
- Saralaya, V.; Shenoy, S.; Baliga, S.; Hegde, A.; Adhikari, P.; Chakraborty, A. Characterization of Escherichia coli phylogenetic groups associated with extraintestinal infections in South Indian population. Ann. Med. Health Sci. Res. 2015, 5, 241. [Google Scholar] [CrossRef]
- Picard, B.; Garcia, J.S.; Gouriou, S.; Duriez, P.; Brahimi, N.; Bingen, E.; Elion, J.; Denamur, E. The link between phylogeny and virulence in Escherichia coli extraintestinal infection? Infect. Immun. 1999, 67, 546–553. [Google Scholar] [CrossRef]
- Kohoutova, D.; Smajs, D.; Moravkova, P.; Cyrany, J.; Moravkova, M.; Forstlova, M.; Cihak, M.; Rejchrt, S.; Bures, J. Escherichia coli strains of phylogenetic group B2 and D and bacteriocin production are associated with advanced colorectal neoplasia. BMC Infect. Dis. 2014, 14, 733. [Google Scholar] [CrossRef]
- Nowrouzian, F.L.; Wold, A.E.; Adlerberth, I. Escherichia coli Strains Belonging to Phylogenetic Group B2 Have Superior Capacity to Persist in the Intestinal Microflora of Infants. J. Infect. Dis. 2005, 191, 1078–1083. [Google Scholar] [CrossRef] [PubMed]
- Johnson, J.R.; Stell, A.L. Extended Virulence Genotypes of Escherichia coli Strains from Patients with Urosepsis in Relation to Phylogeny and Host Compromise. J. Infect. Dis. 2000, 181, 261–272. [Google Scholar] [CrossRef] [PubMed]
- Dahwash, S.M.; Raheema, R.H.; Albahadili, M.A.; Maslat, A.H. Distribution of Phylogenetics and Virulence Genes of Uropathogenic Escherichia coli Among Urinary Tract Infection in Pregnant Women. Biochem. Cell Arch. 2021, 21, 449–456. [Google Scholar]
- Iranpour, D.; Hassanpour, M.; Ansari, H.; Tajbakhsh, S.; Khamisipour, G.; Najafi, A. Phylogenetic Groups of Escherichia coli Strains from Patients with Urinary Tract Infection in Iran Based on the New Clermont Phylotyping Method. BioMed Res. Int. 2015, 2015, 846219. [Google Scholar] [CrossRef] [PubMed]
- Rezatofighi, S.E.; Mirzarazi, M.; Salehi, M. Virulence genes and phylogenetic groups of uropathogenic Escherichia coli isolates from patients with urinary tract infection and uninfected control subjects: A case-control study. BMC Infect. Dis. 2021, 21, 361. [Google Scholar] [CrossRef]
- Regua-Mangia, A.H.; Irino, K.; Pacheco, R.D.S.; Bezerra, R.M.P.; Périssé, A.R.S.; Teixeira, L.M. Molecular characterization of uropathogenic and diarrheagenic Escherichia coli pathotypes. J. Basic Microbiol. 2010, 50, S107–S115. [Google Scholar] [CrossRef]
- Grude, N.; Potaturkina-Nesterova, N.I.; Jenkins, A.; Strand, L.; Nowrouzian, F.L.; Nyhus, J.; Kristiansen, B.-E. A comparison of phylogenetic group, virulence factors and antibiotic resistance in Russian and Norwegian isolates of Escherichia coli from urinary tract infection. Clin. Microbiol. Infect. 2007, 13, 208–211. [Google Scholar] [CrossRef]
- Nicolas-Chanoine, M.-H.; Bertrand, X.; Madec, J.-Y. Escherichia coli ST131, an Intriguing Clonal Group. Clin. Microbiol. Rev. 2014, 27, 543–574. [Google Scholar] [CrossRef]
- Banerjee, R.; Johnson, J.R. A new clone sweeps clean: The enigmatic emergence of Escherichia coli Sequence Type 131. Antimicrob. Agents Chemother. 2014, 58, 4997–5004. [Google Scholar] [CrossRef]
- Pitout, J.D.D.; DeVinney, R. Escherichia coli ST131: A multidrug-resistant clone primed for global domination. F1000Research 2017, 6, 1–7. [Google Scholar] [CrossRef]
- Colpan, A.; Johnston, B.; Porter, S.; Clabots, C.; Anway, R.; Thao, L.; Kuskowski, M.A.; Tchesnokova, V.; Sokurenko, E.V.; Johnson, J.R.; et al. Escherichia coli sequence type 131 (ST131) subclone H30 as an emergent multidrug-resistant pathogen among US veterans. Clin. Infect. Dis. 2013, 57, 1256–1265. [Google Scholar] [CrossRef] [PubMed]
- Hussain, A.; Ewers, C.; Nandanwar, N.; Guenther, S.; Jadhav, S.; Wieler, L.H.; Ahmed, N. Multiresistant Uropathogenic Escherichia coli from a Region in India Where Urinary Tract Infections Are Endemic: Genotypic and Phenotypic Characteristics of Sequence Type 131 Isolates of the CTX-M-15 Extended-Spectrum-β-Lactamase-Producing Lineage. Antimicrob. Agents Chemother. 2012, 56, 6358–6365. [Google Scholar] [CrossRef] [PubMed]
- Williamson, D.A.; Freeman, J.T.; Porter, S.; Roberts, S.; Wiles, S.; Paterson, D.L.; Johnson, J.R. Clinical and molecular correlates of virulence in Escherichia coli causing bloodstream infection following transrectal ultrasound-guided (TRUS) prostate biopsy. J. Antimicrob. Chemother. 2013, 68, 2898–2906. [Google Scholar] [CrossRef] [PubMed]
- Sarowska, J.; Futoma-Koloch, B.; Jama-Kmiecik, A.; Frej-Madrzak, M.; Ksiazczyk, M.; Bugla-PLoSkonska, G.; Choroszy-Krol, I. Virulence factors, prevalence and potential transmission of extraintestinal pathogenic Escherichia coli isolated from different sources: Recent reports. Gut Pathog. 2019, 11, 10. [Google Scholar] [CrossRef] [PubMed]
- Sannes, M.R.; Kuskowski, M.A.; Owens, K.; Gajewski, A.; Johnson, J.R. Virulence Factor Profiles and Phylogenetic Background of Escherichia coli Isolates from Veterans with Bacteremia and Uninfected Control Subjects. J. Infect. Dis. 2004, 190, 2121–2128. [Google Scholar] [CrossRef] [PubMed]
- Khasheii, B.; Anvari, S.; Jamalli, A. Frequency evaluation of genes encoding siderophores and the effects of different concentrations of Fe ions on growth rate of uropathogenic Escherichia coli. Iran J. Microbiol. 2016, 8, 359–365. [Google Scholar]
- Searle, L.J.; Méric, G.; Porcelli, I.; Sheppard, S.K.; Lucchini, S. Variation in siderophore biosynthetic gene distribution and production across environmental and faecal populations of Escherichia coli. PLoS ONE 2015, 10, e0117906. [Google Scholar] [CrossRef]
- Sabri, M.; Léveillé, S.; Dozois, C.M. A SitABCD homologue from an avian pathogenic Escherichia coli strain mediates transport of iron and manganese and resistance to hydrogen peroxide. Microbiology 2006, 152, 745–758. [Google Scholar] [CrossRef]
- Wijetunge, D.S.S.; Gongati, S.; DebRoy, C.; Kim, K.S.; Couraud, P.O.; Romero, I.A.; Weksler, B.; Kariyawasam, S. Characterizing the pathotype of neonatal meningitis causing Escherichia coli (NMEC). BMC Microbiol. 2015, 15, 211. [Google Scholar] [CrossRef]
- Flanagan, J.; Willcox, M. Role of lactoferrin in the tear film. Biochimie 2009, 91, 35–43. [Google Scholar] [CrossRef]
- Spurbeck, R.R.; Stapleton, A.E.; Johnson, J.R.; Walk, S.T.; Hooton, T.M.; Mobley, H.L. Fimbrial profiles predict virulence of uropathogenic Escherichia coli Strains: Contribution of Ygi and Yad fimbriae. Infect. Immun. 2011, 79, 4753–4763. [Google Scholar] [CrossRef] [PubMed]
- Blanco, M.; Blanco, J.E.; Alonso, M.P.; Mora, A.; Balsalobre, C.; Munoa, F.; Juárez, A.; Blanco, J. Detection of pap, sfa and afa adhesin-encoding operons in uropathogenic Escherichia coli strains: Relationship with expression of adhesins and production of toxins. Res. Microbiol. 1997, 148, 745–755. [Google Scholar] [CrossRef]
- Antão, E.M.; Wieler, L.H.; Ewers, C. Adhesive threads of extraintestinal pathogenic Escherichia coli. Gut Pathog. 2009, 1, 22. [Google Scholar] [CrossRef] [PubMed]
- Rendón, M.A.; Saldaña, Z.; Erdem, A.L.; Monteiro-Neto, V.; Vázquez, A.; Kaper, J.B.; Puente, J.L.; Girón, J.A. Commensal and pathogenic Escherichia coli use a common pilus adherence factor for epithelial cell colonization. Proc. Natl. Acad. Sci. USA 2007, 104, 10637–10642. [Google Scholar] [CrossRef] [PubMed]
- Li, B.; Koch, W.H.; Cebula, T.A. Detection and characterization of the fimA gene of Escherichia coli O157:H7. Mol. Cell Probes. 1997, 11, 397–406. [Google Scholar] [CrossRef]
- Müller, C.M.; Åberg, A.; Straseviçiene, J.; Emődy, L.; Uhlin, B.E.; Balsalobre, C. Type 1 fimbriae, a colonization factor of uropathogenic Escherichia coli, are controlled by the metabolic sensor CRP-cAMP. PLoS Pathog. 2009, 5, e1000303. [Google Scholar] [CrossRef]
- Connell, I.; Agace, W.; Klemm, P.; Schembri, M.; Mărild, S.; Svanborg, C. Type 1 fimbrial expression enhances Escherichia coli virulence for the urinary tract. Proc. Natl. Acad. Sci. USA 1996, 93, 9827–9832. [Google Scholar] [CrossRef]
- Hull, R.A.; Donovan, W.H.; Del Terzo, M.; Stewart, C.; Rogers, M.; Darouiche, R.O. Role of Type 1 Fimbria- and P Fimbria-Specific Adherence in Colonization of the Neurogenic Human Bladder by Escherichia coli. Infect. Immun. 2002, 70, 6481–6484. [Google Scholar] [CrossRef]
- Vizcarra, I.A.; Hosseini, V.; Kollmannsberger, P.; Meier, S.; Weber, S.S.; Arnoldini, M.; Ackermann, M.; Vogel, V. How type 1 fimbriae help Escherichia coli to evade extracellular antibiotics. Sci. Rep. 2016, 6, 18109. [Google Scholar] [CrossRef]
- Labbate, M.; Zhu, H.; Thung, L.; Bandara, R.; Larsen, M.R.; Willcox, M.D.P.; Givskov, M.; Rice, S.A.; Kjelleberg, S. Quorum-Sensing Regulation of Adhesion in Serratia marcescens MG1 Is Surface Dependent. J. Bacteriol. 2007, 189, 2702–2711. [Google Scholar] [CrossRef]
- Huang, S.H.; Wan, Z.S.; Chen, Y.H.; Jong, A.Y.; Kim, K.S. Further characterization of Escherichia coli brain microvascular endothelial cell invasion gene ibeA by deletion, complementation, and protein expression. J. Infect. Dis. 2001, 183, 1071–1078. [Google Scholar] [CrossRef] [PubMed]
- Cieza, R.J.; Hu, J.; Ross, B.N.; Sbrana, E.; Torres, A.G. The IbeA invasin of adherent-invasive Escherichia coli mediates interaction with intestinal epithelia and macrophages. Infect. Immun. 2015, 83, 1904–1918. [Google Scholar] [CrossRef] [PubMed]
- Flechard, M.; Cortes, M.A.M.; Reperant, M.; Germon, P. New Role for the ibeA Gene in H2O2 Stress Resistance of Escherichia coli. J. Bacteriol. 2012, 194, 4550–4560. [Google Scholar] [CrossRef]
- Che, X.; Chi, F.; Wang, L.; Jong, T.D.; Wu, C.H.; Wang, X.; Huang, S.H. Involvement of IbeA in meningitic Escherichia coli K1-induced polymorphonuclear leukocyte transmigration across brain endothelial cells. Brain Pathol. 2011, 21, 389–404. [Google Scholar] [CrossRef] [PubMed]
- Wiles, T.J.; Mulvey, M.A. The RTX pore-forming toxin α-hemolysin of uropathogenic Escherichia coli: Progress and perspectives. Futur. Microbiol. 2013, 8, 73–84. [Google Scholar] [CrossRef]
- Wang, C.; Li, Q.; Lv, J.; Sun, X.; Cao, Y.; Yu, K.; Miao, C.; Zhang, Z.-S.; Yao, Z.; Wang, Q. Alpha-hemolysin of uropathogenic Escherichia coli induces GM-CSF-mediated acute kidney injury. Mucosal. Immunol. 2019, 13, 22–33. [Google Scholar] [CrossRef] [PubMed]
- Bailey, M.J.A.; Koronakis, V.; Schmoll, T.; Hughes, C. Escherichia coli HIyT protein, a transcriptional activator of haemolysin synthesis and secretion, is encoded by the rfaH (sfrB) locus required for expression of sex factor and lipopolysaccharide genes. Mol. Microbiol. 1992, 6, 1003–1012. [Google Scholar] [CrossRef]
- Kerényi, M.; Allison, H.E.; Bátai, I.; Sonnevend, A.; Emödy, L.; Plaveczky, N.; Pál, T. Occurrence of hlyA and sheA genes in extraintestinal Escherichia coli strains. J. Clin. Microbiol. 2005, 43, 2965–2968. [Google Scholar] [CrossRef]
- Beutin, L.; Prada, J.; Zimmermann, S.; Stephan, R.; Ørskov, I.; Ørskov, F. Enterohemolysin, a new type of hemolysin produced by some strains of enteropathogenic E. coli (EPEC). Zent. Bakteriol. Mikrobiol. Hygiene. Ser. A Med. Microbiol. Infect. Dis. Virol. Parasitol. 1988, 267, 576–588. [Google Scholar] [CrossRef]
- Boczek, L.A.; Johnson, C.H.; Rice, E.W.; Kinkle, B.K. The Widespread Occurrence of the Enterohemolysin Gene ehlyA Among Environmental Strains of Escherichia coli. Proc. Water Environ. Fed. 2009, 2009, 2992–2995. [Google Scholar] [CrossRef]
- Schwidder, M.; Heinisch, L.; Schmidt, H. Genetics, Toxicity, and Distribution of Enterohemorrhagic Escherichia coli Hemolysin. Toxins 2019, 11, 502. [Google Scholar] [CrossRef] [PubMed]
- Putra, I.; Rabiee, B.; Anwar, K.N.; Gidfar, S.; Shen, X.; Babalooee, M.; Ghassemi, M.; Afsharkhamseh, N.; Bakhsh, S.; Missiakas, D.; et al. Staphylococcus aureus alpha-hemolysin impairs corneal epithelial wound healing and promotes intracellular bacterial invasion. Exp. Eye Res. 2019, 181, 263–270. [Google Scholar] [CrossRef] [PubMed]
- Johnson, M.K.; Allen, J.H. The role of hemolysin in corneal infections with Pseudomonas aeruginosa. Investig. Ophthalmol. Vis. Sci. 1978, 17, 480–483. [Google Scholar]
- Stevens, S.X.; Jensen, H.G.; Jett, B.D.; Gilmore, M.S. A hemolysin-encoding plasmid contributes to bacterial virulence in experimental Enterococcus faecalis endophthalmitis. Investig. Ophthalmol. Vis. Sci. 1992, 33, 1650–1656. [Google Scholar]
- Beecher, D.J.; Pulido, J.S.; Barney, N.P.; Wong, A.C. Extracellular virulence factors in Bacillus cereus endophthalmitis: Methods and implication of involvement of hemolysin BL. Infect. Immun. 1995, 63, 632–639. [Google Scholar] [CrossRef]
- Callegan, M.C.; Jett, B.D.; Hancock, L.E.; Gilmore, M.S. Role of Hemolysin BL in the Pathogenesis of Extraintestinal Bacillus cereus Infection Assessed in an Endophthalmitis Model. Infect. Immun. 1999, 67, 3357–3366. [Google Scholar] [CrossRef]
- Mohammed, A.A.; Ali, M.M.; Zenebe, M.H. Bacterial etiology of ocular and periocular infections, antimicrobial susceptibility profile and associated factors among patients attending eye unit of Shashemene comprehensive specialized hospital, Shashemene, Ethiopia. BMC Ophthalmol. 2020, 20, 124. [Google Scholar] [CrossRef]
- Getahun, E.; Gelaw, B.; Assefa, A.; Assefa, Y.; Amsalu, A. Bacterial pathogens associated with external ocular infections alongside eminent proportion of multidrug resistant isolates at the University of Gondar Hospital, northwest Ethiopia. BMC Ophthalmol. 2017, 17, 151. [Google Scholar] [CrossRef]
- Ranjith, K.; Arunasri, K.; Reddy, G.S.; Adicherla, H.; Sharma, S.; Shivaji, S. Global gene expression in Escherichia coli, isolated from the diseased ocular surface of the human eye with a potential to form biofilm. Gut Pathog. 2017, 9, 15. [Google Scholar] [CrossRef]
- Huang, J.; Zhang, S.; Zhang, S.; Zhao, Z.; Cao, Y.; Chen, M.; Li, B. A Comparative Study of Fluoroquinolone-Resistant Escherichia coli Lineages Portrays Indistinguishable Pathogenicity- and Survivability-Associated Phenotypic Characteristics Between ST1193 and ST131. Infect. Drug Resist. 2020, 13, 4167–4175. [Google Scholar] [CrossRef]
- Okesola, A.; Salako, A. Microbiological profile of bacterial conjunctivitis in Ibadan, Nigeria. Ann. Ib. Postgrad. Med. 2011, 8, 20–24. [Google Scholar] [CrossRef] [PubMed]
- Zhai, H.; Bispo, P.J.; Kobashi, H.; Jacobs, D.; Gilmore, M.S.; Ciolino, J.B. Resolution of fluoroquinolone-resistant Escherichia coli keratitis with a PROSE device for enhanced targeted antibiotic delivery. Am. J. Ophthalmol. Case Rep. 2018, 12, 73–75. [Google Scholar] [CrossRef] [PubMed]
- Rameshkumar, G.; Ramakrishnan, R.; Shivkumar, C.; Meenakshi, R.; Anitha, V.; Reddy, Y.C.V.; Maneksha, V. Prevalence and antibacterial resistance patterns of extended-spectrum beta-lactamase producing Gram-negative bacteria isolated from ocular infections. Indian J. Ophthalmol. 2016, 64, 303–311. [Google Scholar] [CrossRef] [PubMed]
- Asbell, P.A.; Sanfilippo, C.M.; Mah, F.S. Antibiotic susceptibility of bacterial pathogens isolated from the aqueous and vitreous humor in the Antibiotic Resistance Monitoring in Ocular micRoorganisms (ARMOR) Surveillance Study: 2009–2020 update. J. Glob. Antimicrob. Resist. 2022, 29, 236–240. [Google Scholar] [CrossRef] [PubMed]
- Reid, G.; Sobel, J.D. Bacterial Adherence in the Pathogenesis of Urinary Tract Infection: A Review. Clin. Infect. Dis. 1987, 9, 470–487. [Google Scholar] [CrossRef]
Publisher’s Note: MDPI stays neutral with regard to jurisdictional claims in published maps and institutional affiliations. |
© 2022 by the authors. Licensee MDPI, Basel, Switzerland. This article is an open access article distributed under the terms and conditions of the Creative Commons Attribution (CC BY) license (https://creativecommons.org/licenses/by/4.0/).